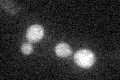
YJL137C
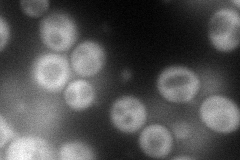
YJL137C
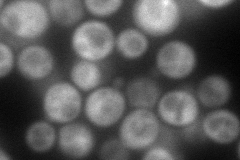
YJL137C

View description
Self-glucosylating initiator of glycogen synthesis, also glucosylates n-dodecyl-beta-D-maltoside; similar to mammalian glycogenin
Localization:
Intensity:
Fold change:
Significance:
-
C’ GFP library in SD
cytosol20.29 -
N' NOP1pr-GFP in SD
cytosol86.6431 -
N' TEF2pr-mCherry in SD
cytosol126.562 -
N' NATIVEpr-GFP in SD

cytosol21.0889 -
N' TEF2pr-VC and Cyto-VN in SD

cytosol56.2554 -
C’ GFP library in SD+DTT

cytosol20.711.02No -
C’ GFP library in SD+H2O2

cytosol20.971.03No -
C’ GFP library in Starvation Media

cytosol45.462.23No -
C’ GFP library on the background of Pup2-DaMP

cytosol -
C’ GFP library on the background of CCT mutant

cytosol19.63140.967243No
